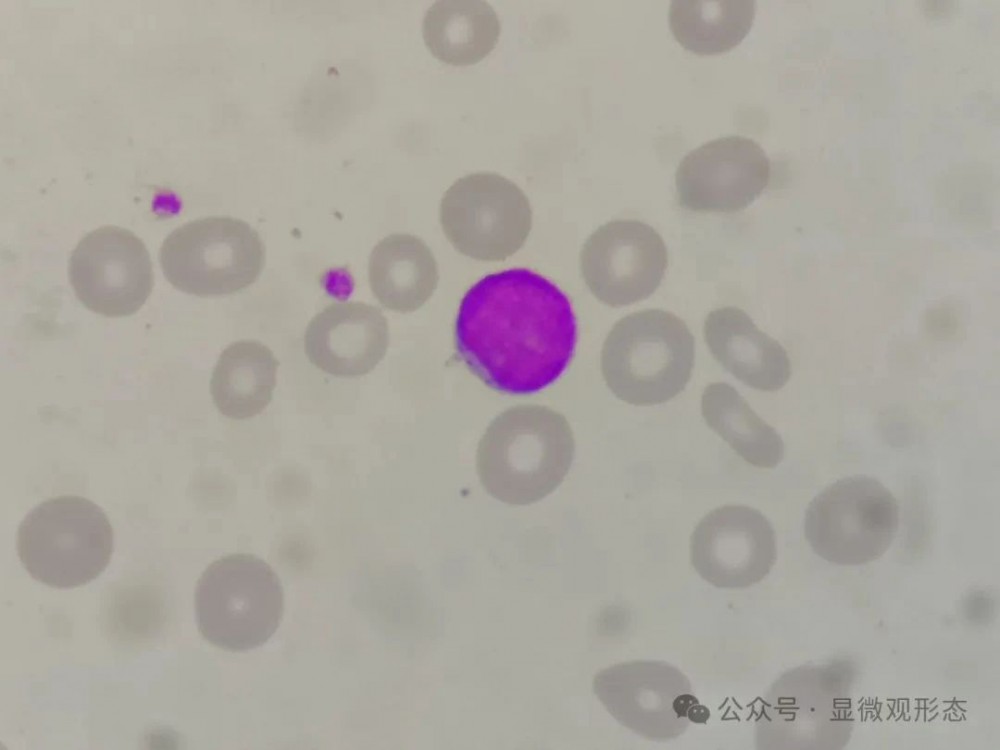

若能独具慧眼,它将插翅难逃④
病例起源
患者,女,50+岁,骨髓增生异常综合征患者,检查外周血细胞形态及性质分析,血细胞分析结果如下:

仪器报警信息如下:

仪器有异常淋巴细胞/原始细胞?未成熟细胞?核左移?血小板聚集等报警,散点图貌似没有太大异常(至少小编看不出太大异常,除了中性粒细胞在横坐标上左移之外)。
形态特征
外周血涂片,以下所有图片瑞吉染色,在油镜(1000倍)下,手机放大约3.5倍拍摄。

外周血细胞形态分类:中性杆状核粒细胞占1%,中性分叶核粒细胞占47%,淋巴细胞占34%,单核细胞占10%,嗜酸性粒细胞占1%,嗜碱性粒细胞占1%,原始细胞占6%。
备注:前5张倾向原始细胞,后3张倾向裸核型巨核细胞。
简要病史
现病史:3年余前患者磕碰后出现皮肤瘀斑,无牙龈出血、鼻出血等出血症状,无头痛、头晕,就诊于我院行化验示血小板减少(具体数值不祥),未给予特殊治疗。之后上述症状间断出现,均未给予特殊诊治。后患者自诉血尿,伴牙龈出血,无头晕、心悸,就诊于我院门诊,行化验示血常规:WBC5.04×10e9/L(10e9表示10的9次方,下同),HGB 91g/L,MCV 91.5fl,PLT 66×10e9/L,RET 3.4%。完善骨髓等相关检查,骨髓形态学:增生明显活跃骨髓象;原始细胞占4.6%/单核细胞占13%,请结合临床/建议动态监测。流式细胞学:送检标本中可见0.5%髓系原始细胞;另见较成熟的粒系细胞比例正常;骨髓活检:1.巨核细胞数量不少,红系增生尚可。2.暂不支持白血病、浆细胞骨髓瘤、淋巴瘤累及骨髓组织形态学改变。考虑意义未明血细胞减少,建议上级医院就诊。2022.11就诊于国内某血液病医院,行骨髓等相关检查确诊为骨髓增生异常综合征(MDS-EB2),给予阿扎胞苷+维奈克拉治疗(……),近期患者再感乏力加重,遂来我院以求进一步治疗。
既往史:有高血压病史,输血史。
体格检查:体温:36.0℃,脉搏:86次/分,呼吸:20次/分,血压:120/80mmHg。轻度贫血貌,皮肤颜色、口唇苍白。
其他检查
外周血报告原始细胞约占6%,本次住院完善骨髓穿刺检查,结果如下:
骨髓检验结果:骨髓增生活跃,涂片原始细胞约占15.5%,病态细胞易见,请结合活检、流式细胞、染色体及基因等检查。
流式细胞免疫荧光分析结果:骨髓中可见异常髓系原始细胞(约占有核细胞的4.27%),结合临床符合骨髓增生异常综合征,请结合形态学及遗传学检查。
骨髓活检结果:骨髓增生活跃,粒系优势增生伴核左移及ALIP,原始细胞占比约12-15%,巨核细胞增生活跃伴异型,考虑骨髓增生异常综合征伴原始细胞增多(MDS-EB 2),请结合临床及染色体等检查,建议做MDS相关基因突变等检查。
染色体核型分析:46,XX[20]。
个人体会
该患者既往诊断过骨髓增生异常综合征,本次血细胞分析示白细胞、红细胞、血红蛋白、血小板均减低,散点图小编看不出太大问题(见01部分),镜检可见原始细胞约占6%,及时提示临床。临床完善骨髓穿刺检查,仍提示骨髓增生异常综合征伴原始细胞增多。
此病例提醒我们,不仅要重视血细胞计数,也需要多去结合仪器报警和散点图等信息,特别要重视病史,尤其外周血原始细胞比例不高时,能做到不漏检,才能更好地为临床提供可靠的诊疗依据。
内容来源 | 显微观形态

